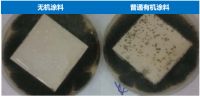
超高层建筑消防难题何解？铃鹿无机涂料不惧火情！

[家具相关知识] 全友全屋定制怎么样?无主灯+强收纳,113㎡氛围感拉满!
12/09/2022 15:43
本案业主为齐女士夫妇,二人皆就职于银行,出于日常工作上的细致要求,他们对于房屋装修也有着较高标准。齐女士首先向我们表达了实用诉求:出入便利、空间收纳、客人留宿,在兼顾功能的同时,夫妻二人也希望能...
>> 查看全文
[家具相关知识] 超高层建筑消防难题何解?铃鹿无机涂料不惧火情!
12/09/2022 11:05
长沙电信大厦火灾再敲警钟 :前不久,位于湖南长沙市区内的中国电信大楼发生火灾,现场浓烟滚滚,数十层楼体燃烧剧烈。尽管这次火灾没有造成人员伤亡,但也再次敲响高层建筑防火警钟。...
>> 查看全文
[家具相关知识] 浦玮、黄健翔、刘语熙齐聚左右沙发直播间,与大家侃球、发放福利
12/09/2022 09:12
四年一度的足球盛事,正在如火如荼进行。这一届足球盛宴你想怎么看,是躺着看还是坐着看? 在家看球,当然享受最重要!12月12日晚8点,左右首席看球官、前女足国家队队长浦玮将走进左右沙发官方直...
>> 查看全文
[家具相关知识] 孩子爱流鼻血怎么办?升级5A级室内空气刻不容缓
12/08/2022 19:27
冬季天气干燥,很多孩子会出现皮肤过敏,甚至流鼻血的症状。对此,一些家长只是简单止血了之,殊不知可能是家里空气出了问题。事实上,空气中很多有害物质都可能让孩子感到不适,如果置之不理,不仅会造成皮肤...
>> 查看全文
[家具相关知识] 入住新家新屋怎样除甲醛?学会这些不到两个月就能住
12/08/2022 17:28
有许多小伙伴在买了房子之后,苦于除甲醛时间太长,自己迟迟无法入住。那么,对于这些急于入住的人群来说,到底新屋怎样除甲醛才是最有效的呢?毕竟在当今发展迅速的社会状态下,快节奏已成为了关键词,相应的...
>> 查看全文